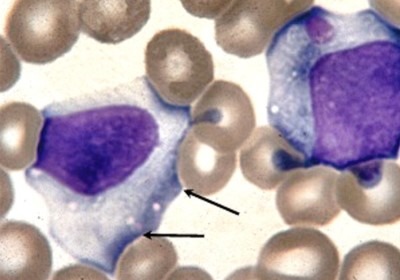

Содержание
Если выявлены атипичные мононуклеары в крови стоит разобраться, на что они указывают. За что отвечают эти клетки? При каких заболеваниях их уровень в крови увеличивается? Чем опасно появление вироцитов у взрослых и детей?
Что такое атипичные мононуклеары?
Мононуклеар представляет собой крупную клетку с одним ядром особо крупных размеров. Атипичными (измененными) мононуклеары становятся действием вируса или инфекции. Для таких клеток характерен большой размер.
Мононуклеары являются фагоцитами, то есть уничтожают вредоносные бактерии, участвуют в общей защите организма. Из-за вирусов клетки изменяются и становятся патогенными (атипичными).
Норма у человека: один два в поле зрения.
Чаще всего у здоровых людей нет атипичных мононуклеаров (вироцитов) или не более 1% .
Если вироцитов больше 10 % – заболевание достигло критической точки.
Атипичные мононуклеары в анализе крови вызывают интерес у врачей, так как их появление может свидетельствовать о различных состояниях организма. Эти клетки, отличающиеся от обычных лимфоцитов, часто ассоциируются с вирусными инфекциями, особенно с инфекционным мононуклеозом, вызванным вирусом Эпштейна-Барр. Однако их наличие не всегда указывает на инфекцию; атипичные мононуклеары могут возникать также при аутоиммунных заболеваниях, лимфопролиферативных расстройствах и даже в ответ на стрессовые ситуации. Врачи подчеркивают важность комплексного анализа, так как атипичные клетки могут быть лишь одним из множества факторов, указывающих на состояние здоровья пациента. Правильная интерпретация результатов требует учета клинической картины и дополнительных исследований.

Как правильно сдавать анализ крови

Для правдивого результата важно правильно провести забор крови на анализ. Кровь сдается утром, до завтрака. Употреблять пищу, соки, сладкие напитки нельзя. Также следует ограничить физические нагрузки. Перед забором крови следует посидеть минут 20 перед кабинетом.
Важно! Нельзя оценивать результат по одному показателю. Общую картину дает совокупность всех параметров. Не занимайтесь самостоятельной постановкой диагноза. Анализ должен расшифровывать специалист!
В каких случаях вироциты обнаруживаются в крови?
Появление атипичных (базофильных) мононуклеаров могут вызвать:
- Инфекционный мононуклеоз;
- онкологические заболевания;
- вирус иммунодефицита человека;
- аутоиммунные процессы;
- нарушения в составе крови (например, анемия);
- нарушения в работе почек или печени;
- вирусная или бактериальная атака на организм;
- интоксикация организма вследствие отравления или долгого применения лекарств.
У здоровых детей в крови часто встречается небольшое количество мононуклеаров. Это не является тревожным сигналом, если остальные показатели в норме, а состояние ребенка не вызывает опасений.
В любом случае, ставить диагноз по одному анализу нельзя. Назначается комплексное обследование, с целью выявить причину. Анализы и исследования зависят от общего состояния человека.
Атипичные мононуклеары в анализе крови часто вызывают вопросы и беспокойство у пациентов и врачей. Эти клетки, отличающиеся от обычных лимфоцитов, могут свидетельствовать о различных состояниях, включая вирусные инфекции, такие как мононуклеоз, вызванный вирусом Эпштейна-Барр. Люди нередко обсуждают, что наличие атипичных мононуклеаров может указывать на активный иммунный ответ организма на инфекцию.
Причины их появления разнообразны: это не только вирусные инфекции, но и некоторые бактериальные заболевания, а также реакции на лекарства или аллергии. Важно отметить, что атипичные мононуклеары могут быть временным явлением и не всегда требуют серьезного лечения. Однако, если их количество значительно увеличено, это может потребовать дополнительного обследования для исключения более серьезных заболеваний. Поэтому при обнаружении атипичных клеток в анализе крови важно проконсультироваться с врачом для правильной интерпретации результатов.

Инфекционный мононуклеоз
Это инфекционное заболевание чаще поражает детей 3–14 лет. Болеют и взрослые.
Передается при бытовом контакте с носителем или воздушно-капельным путем. Инкубационный период может затянуться до 2 месяцев.
Инфекция локализуется в лимфоузлах, миндалинах, селезенке, реже поражается печень. Основной удар получает иммунная система, так как поражаются клетки-защитники.
Характерный симптом – увеличение лимфоузлов и селезенки на фоне повышенных мононуклеаров в крови. Также возникают: отечность миндалин, увеличение аденоидов, слабость, ночной храп. Повышается температура тела.
При тяжелом течении болезни ярко выражена общая интоксикация организма.
Продолжительность заболевания 15–20 дней. Может протекать бессимптомно. При присоединении бактериальной патогенной флоры развиваются осложнения: ангина, воспаление легких, отит.
В течение года после перенесенного заболевания ребенок наблюдается у гематолога. В крови могут сохраняться атипичные мононуклеары.
Важно после перенесенного мононуклеоза восстановить детское здоровье. Для этого на год ограничиваются физические нагрузки, исключаются прививки. Дети после выздоровления плохо переносят солнечный свет. От загара и нахождения под прямым солнцем лучше отказаться.
В целом мононуклеоз полностью излечивается, не дает критических последствий. Но при тяжелых формах возможны серьезные осложнения.
Лечение назначает врач!
Рекомендуем посмотреть программу Елены Малышевой про мононуклеоз
Лечение и профилактика
Специфической терапии нет. Рекомендуется обильное питье, постельный режим, лечение симптоматическое.
Применяются противоаллергические препараты для снижения отеков.
Если присоединяется бактериальная инфекция, назначается лечение антибиотиками.
Профилактикой может служить поддержка иммунной системы человека. Так как вирусы герпеса вызывают различные заболевания только при ослаблении иммунитета. Следует употреблять витаминные комплексы в весеннее-осенний период, вести здоровый образ жизни, правильно и разнообразно питаться, больше проявлять физическую активность.
Вироциты в анализе указывают на наличие вирусного заболевания. Наиболее вероятно – инфекционного мононуклеоза. Эта болезнь чаще поражает детей. Атипичные мононуклеары – это измененные вирусом лимфоциты. Норма вироцитов в крови здорового человека 0–1%.

Вопрос-ответ
Почему появляются атипичные мононуклеары?
Атипичные мононуклеарные лимфоциты наблюдаются при различных инфекционных заболеваниях. Основная функция этих клеток – захват и уничтожение вирусов и бактерий, в результате чего они увеличиваются в размере. Их количество является ценным диагностическим признаком.
При каком заболевании в мазке крови можно выявить атипичные мононуклеары?
Возможные причины появления атипичных мононуклеаров в крови: инфекционный мононуклеоз, вирусные, бактериальные и грибковые инфекции, аутоиммунные и онкологические заболевания, заболевания крови (полицитемия, лейкоз).
Как долго созраняются атипичные мононуклеары?
Симптомы сохраняются 2-4 недели. С началом периода клинических проявлений в крови обнаруживаются атипичные мононуклеары (> 10 % лимфоцитов) и показатели нарушения функции печени.
Советы
СОВЕТ №1
Обратите внимание на симптомы. Если у вас есть признаки, такие как усталость, лихорадка или увеличение лимфатических узлов, не откладывайте визит к врачу. Атипичные мононуклеары могут указывать на инфекцию или другие заболевания, требующие диагностики.
СОВЕТ №2
Регулярно проходите медицинские обследования. Профилактические анализы крови помогут выявить атипичные мононуклеары на ранних стадиях и предотвратить возможные осложнения. Не забывайте о важности регулярного контроля за состоянием здоровья.
СОВЕТ №3
Изучите информацию о вирусах, вызывающих атипичные мононуклеары. Например, вирус Эпштейна-Барра, вызывающий инфекционный мононуклеоз, может иметь долгосрочные последствия. Знание о причинах поможет вам лучше понять свое состояние и обсудить его с врачом.
СОВЕТ №4
Следите за своим иммунитетом. Здоровый образ жизни, включая сбалансированное питание, физическую активность и достаточный сон, может помочь укрепить иммунную систему и снизить риск инфекций, которые могут привести к появлению атипичных мононуклеаров в крови.

